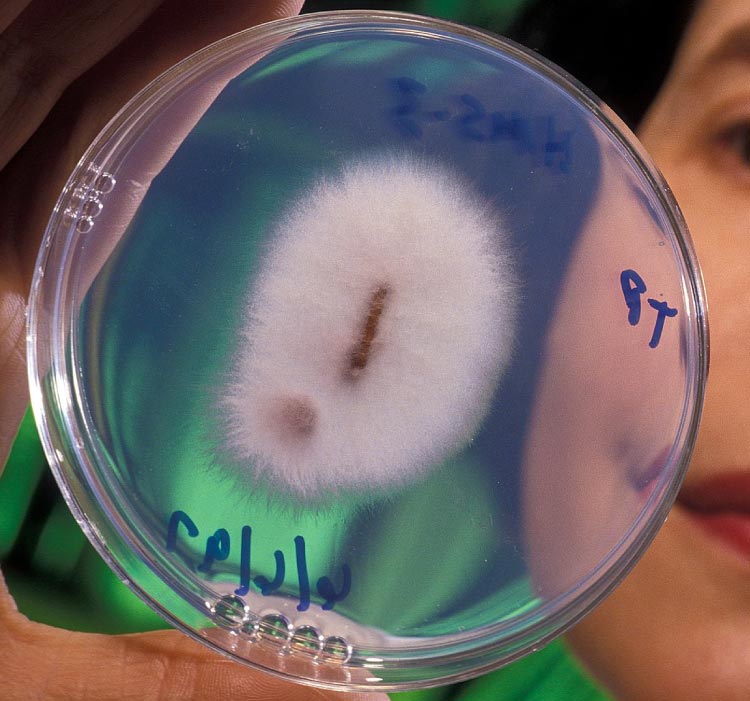
muestra-Fusarium-oxysporum

"Banano ecuatoriano: Una maquinaria de USD 3.800 millones protegida por una inversión de emergencia 'low cost'"
Ante
la emergencia del hongo Fusarium
oxysporum f. sp. cubense Raza 4 Tropical (Foc R4T) en una finca de El
Oro, el gobierno confirmó una asignación de 4.5 millones para enfrentar la
siniestralidad fitosanitaria durante un período de seis meses, según lo ha
indicado Danny Morales, director de la Agencia de
Regulación y Control Fito y Zoosanitario, Agrocalidad, en entrevista con el
diario digital “Primicias”, el pasado viernes 19 de diciembre.
La
inversión se concentrará en 11 de los puntos de desinfección que estarán en la
provincia de El Oro, en el Cantón Santa Rosa, donde el pasado 3 de septiembre
se dio la alarma de un posible foco de infección del hongo Foc R4T. La
provincia de El Oro, aporta aproximadamente entre el 25 y 30% de la exportación
de bananos. La inversión estatal esta protegiendo específicamente cerda de 1050
millones en fruta orense durante los próximos seis meses de emergencia.
El
"Seguro" de una Industria de $3,800 Millones
Ecuador exporta anualmente cerca de 3,838
millones de dólares en banano. Para proteger este gigante económico,
Agrocalidad ha ejecutado una inversión acumulada de 34 millones de dólares
en bioseguridad y tecnología. La reciente asignación financiera es de apenas
4.5 millones que se destinarán para focalizar la contención en un perído de
seis meses en la provincia de El Oro.
Al desglosar las cifras, el esfuerzo
preventivo resulta sorprendente: el Estado ha invertido apenas el 0.06% del
valor de las exportaciones anuales en bioseguridad específica para Foc R4T.
En términos más sencillos, por cada $1,000 dólares que ingresan al país por la
venta de la fruta, solo se han destinado $1.77 a prevenir la llegada del hongo.
¿Qué se hará
con el dinero de la emergencia?
Los 4.5 millones de la emergencia por
Fusarium, se invertiran en acciones como fortalecimiento de laboratorios,
puntos de desinfección en total 35 y contratación de personal para la
contención del hongo. Nada se habla en este rubro de inversiones en desarrollo
de tecnologías, investigación y difusión en medios para concientizar al
productor de la gravedad y riesgo del hongo.
Factores de Riesgo y Oportunidad
- El Oro como Eje: Al haberse detectado el hongo en el
cantón Santa Rosa, la inversión en contratación de personal y laboratorios
garantiza que el principal foco de infección no comprometa la meta de
crecimiento de 2026.
- Negociación Internacional: El aumento del precio a USD 7,50
para 2026 ayuda a los productores a absorber los costos de bioseguridad
interna en las fincas, complementando la inversión estatal de USD 4,5
millones en las vías y fronteras.
El contraste para
el primer semestre de 2026 es favorable USD 2.050 millones, proyección
proyectada considerando el nuevo (PMS $7.50), y la apertura de nuevos mercados.
Mientras que el sector esperar generar un 6,6% más de ingresos en dólares
comparado con 2025, la inversión de emergencia se mantiene como un
"seguro" de bajo costo (0,22% del total de ingresos semestrales) para
garantizar la continuidad del flujo exportador hacia Europa y Asia.
La inversión
representaría apenas el 0,22% de los ingresos totales del semestre. Es decir,
es un “seguro fitosanitario” de muy bajo
costo frente al patrimonio en riesgo. La cifra asignada es un valor infimo
comparado con el margen que general el nuevo precio oficial de la caja.
En
realidad, la inversión de USD 4,5 millones está blindando un
motor económico que genera casi 2 mil millones de dólares cada seis meses.
La relación costo-beneficio es, por tanto para el estado, es una de las más
eficientes en el presupuesto para el año 2026, pero que no garantiza la misma
eficiencia en el control del hongo en las plantaciones de producirse una
expansión del hongo a otras provincias.
La siniestralidad
del hongo Fusarium acarrearía una caída del 10% de las exportaciones bananeras
En un escenario apocalíptico para el sector
bananero que puede agudizarse por la presencia de Moko y la confirmación de la
patogenidad de Fusarium el impacto de una pésima gestión en la efectividad de
los 35 puntos de desinfección es importante hacer una simulación de los riesgos
que se traducirían en tres niveles:
1. Impacto en el Volumen y Divisas
Una brecha
del 10% en bioseguridad podría derivar en la cuarentena de fincas adicionales a
las 7 hectáreas detectadas inicialmente.
- Pérdida estimada en exportación: ~19,8 millones de cajas (10% de la
expectativa semestral).
- Pérdida económica directa: USD 205 millones en el primer
semestre.
- Contraste: Esta pérdida es 45 veces mayor que la inversión total de
emergencia de USD 4,5 millones.
2. Crisis de Empleo y Producción (Especialmente en El Oro)
Dado que 11
puntos de desinfección se concentran en El Oro, una falla en esta zona
afectaría el nodo logístico de Puerto Bolívar.
- Riesgo en fincas: El hongo podría saltar de las 7
hectáreas actuales a zonas aledañas, comprometiendo la producción de
pequeños productores que dependen de la desinfección en vías públicas para
movilizar su fruta.
- Efecto en cascada: La pérdida de confianza del comprador
internacional obligaría a reubicar la fruta en mercados que pagan menos,
reduciendo el ingreso real por caja por debajo de los USD 7,50
proyectados.
3. Degradación de la Relación Costo-Beneficio
En este
escenario negativo, la "ahorrativa" inversión estatal se vuelve
costosa por su ineficacia:
- Inversión actual: USD 4,5 millones.
- Daño colateral: Por cada dólar que el Estado
"ahorra" al no mantener la efectividad al 100%, el sector
privado pierde USD 45.
Resumen del
Escenario de Riesgo
|
Indicador |
Escenario Óptimo (100% efectividad) |
Escenario de Falla (90% efectividad) |
|
Cajas exportadas (semestre) |
198 millones |
178,2 millones |
|
Ingresos percibidos |
USD 2.050 millones |
USD 1.845 millones |
|
Estado de la Inversión |
Preventiva y eficiente |
Insuficiente (Gasto perdido) |
Una caída mínima del 10% en la
efectividad de los controles (por falta de insumos en los puntos, menos
personal o fallas en laboratorios ) anularía
inmediatamente el beneficio de la inversión. El ahorro
aparente de mantener un presupuesto bajo de USD 4,5 millones se convierte en una pérdida patrimonial masiva, ya que el
hongo FOC R4T puede permanecer en el suelo por décadas, afectando
no solo el 2026, sino la capacidad productiva del país a largo plazo.